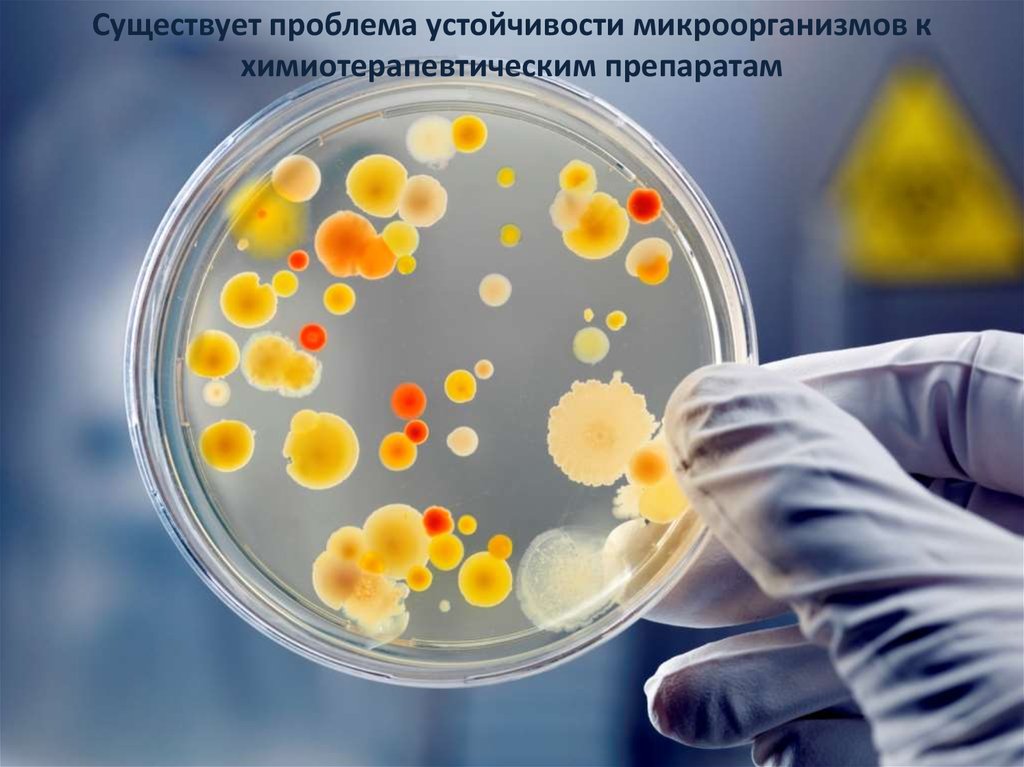

Похожие презентации:
Применение населением Могилевской области противомикробных лекарственных средств в домашних условиях
1.
Применение населением Могилевскойобласти противомикробных лекарственных
средств в домашних условиях
2.
Подготовили:1. Шевцова Виктория Васильевна
2. Тихоновская Анастасия Андреевна
3.
Руководитель:Кунцевич Сергей Сергеевич – преподаватель УО «Могилевский государственный
медицинский колледж»
4.
Существует проблема устойчивости микроорганизмов кхимиотерапевтическим препаратам
5.
Появляются и применяются новыеантибактериальные средства, но проблема не
уменьшается, а возрастает
6.
Что же обуславливает проблему?7.
Необоснованное применениеэтих препаратов в медицине
8.
Широкое применение антибиотиков в животноводстве иптицеводстве
9.
Низкое качество ряда дженериков10.
Распространение необоснованного самолечения11.
В самом ли деле самолечение широко распространено?12.
По поводу каких групп заболеванийприменяются дома противомикробные
лекарства?
13.
Какие группы противомикробных средств наиболеепопулярны у населения?
14.
Цель исследования – определить распространенностьсамолечения с использованием противомикробных
лекарственных средств у населения Могилевской
области
15.
Информация собрана путем опроса и анкетирования16.
83% семей имеют в домашней аптечке противомикробныесредства для приема внутрь
17.
Противомикробные лекарственные средства домашних аптечек вабсолютных цифрах и процентах
№
Наименование лекарства по МНН
1 Амоксициллин
число
125
%
41,5
2
Тетрациклин
26
8,6
3
Ампициллин
25
8,3
4
Эритромицин
20
6,7
5
Пенициллин и его соли
18
6,0
6
Доксициклин
16
5,3
7
Цефалексин
10
3,3
8
Офлоксацин
9
3,0
9
Цифотаксим
8
2,7
10 Цефазолин
7
2,3
11 Цефтриаксон
5
1,7
12 Ципрофлоксацин
5
1,7
13 Цефтриаксон
5
1,7
14 Другие средства
22
7,3
301
100
ИТОГО
18.
Наиболее часто в домашних аптечках присутствует Амоксициллин(41,5%)
19.
Удельный вес групп антибиотиков, находящихся вдомашних аптечках, в %
тетрациклины 15%
пенициллины 59,8%
цефалоспорины 13,6%
фторхинолы 11,6%

Медицина
Медицина








